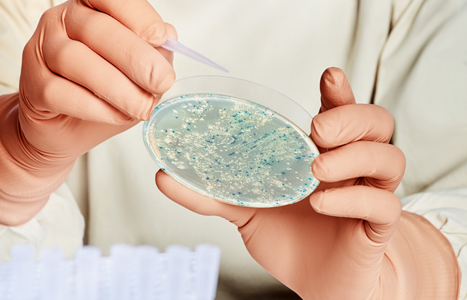
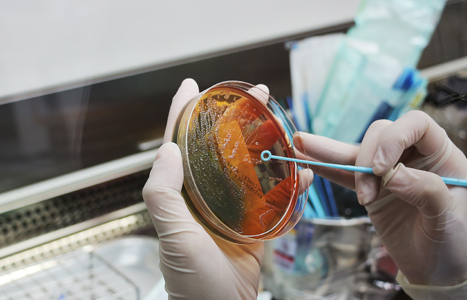

Somos uma empresa especializada na prestação de serviços de análises microbiológicas de alimentos e água, consultoria em segurança alimentar e realização de treinamentos.
Estes programas tornam-se uma ferramenta que visa alcançar os níveis adequados de segurança dos alimentos garantindo sua integridade e a saúde do consumidor.






Lamic Análises Microbiológicas
Bem-vindo a Lamic


Descubra como podemos ajudar sua empresa
Nossos Serviços
Análises
Entre os vários parâmetros que indicam a qualidade e a inocuidade de alimentos, os mais importantes são aqueles que definem...
Consultorias
Com visitas presenciais no seu estabelecimento da área de alimentos, seja uma franquia, um Hotel, restaurante, em feiras e eventos....
Treinamento
Programa de treinamento “In Company” ´já incluso na consultoria técnica e periódica, adequados à realidade e necessidades da cada empresa...
Solicite seu Orçamento
Confiram algumas boas práticas
Dicas de Prevenção
Lavar alimentos
Lavagem em água corrente, colocar em água clorada por 15 minutos e enxaguar em água corrente por 2 minutos.
Manejo de resíduos
A cozinha deve dispor de lixeiras, revestidas com sacos plásticos resistentes, com tampa e com pedal.
Higiene Pessoal
Touca e com uniforme limpo, não usar perfumes, unhas curtas e limpas, e fumar apenas em locais permitidos.
Quais os pilares da LAMIC Análises Microbiológicas?
A questão da higiene não se limita apenas aos processos de limpeza, mas compreendem três aspectos principais: o AMBIENTE, o ALIMENTO e o MANIPULADOR DE ALIMENTOS.
Todos os Serviços
mil
INFECTADOS POR ALIMENTOS NO BRASIL
milhões
INFECTADOS POR ÁGUA NO BRASIL
mil
INFECTADOS POR AR NO BRASIL
Fique por dentro das novidades
Notícias Recentes
Fique bem informado
Dicas Rápidas
Lavagem em água corrente, colocar em solução de água clorada por 15 minutos e enxaguar em água corrente ou imergir em água por 2 minutos.

Lavar bem os alimentosBoas Práticas
A cozinha deve dispor de lixeiras (plástico ou metal, preferencialmente aço inox), revestidas com sacos plásticos resistentes, com tampa e com pedal.

Manejo de ResíduosBoas Práticas
Sempre de touca e com uniforme limpo, não usar perfumes, unhas curtas e limpas, não usar adornos e fumar apenas em locais permitidos.

Higiene PessoalBoas Práticas
Informações de Contato
Rua Abdias Nascimento, 61 Luzia
Aracaju/SE
Aracaju/SE
lamic@lamic.com.br
(79) 3211-2203